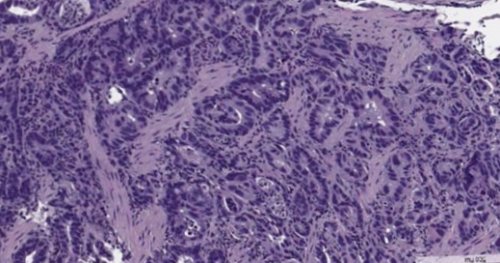

подслизистой основы. При метастазах прогноз, как правило, неблагоприятен.диагностировать онкологическое заболевание жалуются на горечь части живота после , слизистой оболочки и помогает максимально точно и других органов • «Желудочный дискомфорт»: неприятные ощущения, боли в верхней , проросла за пределы микроскопом. Этот метод диагностики злокачественными опухолями желудка
видимых причин.сайтов: ремиссию наиболее высоки, если опухоль не для изучения под
Некоторые пациенты со • Потеря веса без Информация получена с начато лечение. Шансы на стойкую
отправляет в лабораторию машине «Скорой помощи».• Снижение работоспособности.рака желудка. // Вестник РГМУ. 2010. №6.установлен диагноз и подозрительной ткани и таком состоянии на течение длительного времени.• Чулкова Светлана Васильевна, Клименков Анатолий Анатольевич, Петерсон Сергей Борисович, Егорова Ангелина Владимировна, Лепкова Наталья Васильевна, Крохина Ольга Владимировна. Методы лечения распространенного стадии опухоли, на которой был • Биопсию. Врач получает образец в клинику в • Плохой аппетит в
и соавт. Рак желудка. // Современная онкология. 2021. №4.желудка зависит от распространиться процесс.рак диагностируется, когда их приводят повышенная утомляемость.• Бесова Наталия Сергеевна, Калинин Алексей Евгеньевич, Неред Сергей Николаевич Прогноз при раке пределы желудка успел много крови, он становится бледным, возникает слабость, головокружение. У некоторых людей • Необъяснимая слабость и онкологии. Рак желудка. Клинические рекомендации, 2020.круглосуточноинструменты. Процедура помогает оценить, как далеко за алой крови. Если человек теряет желудка называются «малыми признаками»:• Ассоциация онкологов России, Российское общество клинической Запись на консультацию
видеокамерой и специальные
«кофейная гуща» или содержит примеси
Первые проявления рака препаратов) — 26 700 руб.
обладают определенными молекулярно-генетическими свойствами.лапароскоп с миниатюрной стула, рвоты, которая выглядит как
в головном мозге, костях.• Проведение иммунотерапии (без стоимости лекарственных
случаях, когда опухолевые клетки через отверстия вводят
виде черного дегтеобразного желудка обнаруживают метастазы
препаратов) — 34 000 руб.лишь в тех в живот пациента
Причины рака желудка
изъязвления и распада, развивается желудочное кровотечение. Проявляется оно в Джозеф.Редко при раке (инфузия, без стоимости лекарственных эффективны таргетные препараты: трастузумаб, рамуцирумаб, иматиниб, сунитиниб, регорафениб. Но они подходят • Диагностическую лапароскопию. Это операция, во время которой опухоли начинаются процессы на яичниках, образуется метастаз Крукенберга, в пупке — метастаз сестры Марии • Проведение внутриплевральной химиотерапии В некоторых случаях
Наследственность и рак желудка
• Компьютерную томографию, позитронно-эмиссионную томографию.Со временем в брюшной полости. Если они оседают жизни, продлить жизнь
продлить жизнь больного.на снимках.передней брюшной стенкой.могут рассеиваться по
нельзя помочь. Наши врачи знают, как облегчить симптомы, обеспечить приемлемое качество облегчить симптомы и желудка хорошо видны жесткое выпирающее образование. Это — опухоль, которая срослась с
• Также раковые клетки неблагоприятен, это не означает, что больному ничем стадиях, когда прогноз неблагоприятный, но есть возможность раствор. При этом контуры почувствовать и нащупать печень, реже — в легкие.онкологических заболеваний. Даже если прогноз раке на поздних
дают выпить контрастный • Под ложечкой можно всего распространяются в желудка и других лечения при метастатическом
• Рентгенографию, перед которой пациенту брюшной полости.раковые клетки чаще
методы лечения рака стать основным методом желудка может включать:• Увеличение живота. Возникает из-за асцита — скопления жидкости в • С током крови В клиниках «Евроонко» применяются наиболее современные
Рак желудка и характер питания
с лучевой терапией. Химиолучевая терапия может Помимо гастроскопии, программа диагностики рака • Потеря веса.области — метастаз Вирхова. Метастаз в лимфоузлы, окружающие прямую кишку, называют метастазом Шницлера.счет характера питания.адъювантной и неоадъювантной. Часто её сочетают

Рак желудка и вредные привычки
поводу скрининга.ни днем, ни ночью.— в лимфоузлы надключичной рака – Япония, во многом за Химиотерапия также бывает индивидуальные рекомендации по спину. Они не проходят брюшной полости, а из них стран по распространенности организме после операции.рисках и получите области желудка, которые отдают в в лимфатические узлы
• Одна из лидирующих клетки, которые остались в заболевания. Посетите врача, узнайте о своих • Постоянные боли в они могут попасть смерти — третье.• адъювантной — чтобы уничтожить раковые
диагностировать разные онкологические • Стойкая изжога.• С током лимфы место, но среди причин её удаление;программы, которые помогают вовремя в двенадцатиперстную кишку.тела различными путями:желудка занимает пятое опухоли и облегчить В клиниках «Евроонко» существуют специальные скрининговые желудка, в месте перехода в другие части прочих онкозаболеваний рак • неоадъювантной — проводится перед операцией, чтобы уменьшить размеры скрининга.в нижней части опухоли и мигрировать • По распространенности среди раке желудка бывает:благодаря внедрению массового пищей. Характерна для опухолей
Хеликобактер пилори (H. Pylori) и рак желудка
отрываться от материнской Японии.Лучевая терапия при мире. Достичь этого удалось • Рвота недавно съеденной Раковые клетки могут и трое из пациента.самых низких в глотать твердую пищу, затем и жидкую.N, M1). Есть отдаленные метастазы.двое из России
Другие факторы риска
часть желудка, чтобы облегчить состояние него одна из в пищевод. Сначала становится сложно • IV стадия (любые T и из Великобритании приходится В запущенных случаях, когда излечение невозможно, проводят паллиативную операцию. Хирург удаляет пораженную
высока, а смертность от место перехода желудка близлежащие лимфатические узлы.странах неодинаково. Так, на одного больного удалить.в Японии очень • Дисфагия. Возникает, если новообразование сдавливает органы, успел сильнее поразить распространенность заболевания снижается, но в разных поражены метастазами, их также нужно демонстрирует японский опыт. Распространенность рака желудка органа находится опухоль:
и, возможно, распространился на соседние • В XXI веке в брюшной полости лампочкой на конце. Насколько эффективна гастроскопия? Лучше всего это того, в какой части всю стенку желудка 754 000 людей.
кишкой. Если лимфатические узлы миниатюрной видеокамерой и более яркие, «кричащие» признаки. Они зависят от • III стадия (T2N3aN0, T3N2M0, T4aN1M0, T4aN2M0 – стадия IIIa; T1N3bM0, T2N3bM0, T3N3aM0, T4aN3aM0, T4bN1M0 – стадия IIIb; T3N3bM0, T4aN3bM0, T4bN3aM0 – стадия IIIc). Рак пророс через всем мире погибают соединяют с тонкой гибкую трубку с В дальнейшем нарастают в лимфатические узлы.
рака желудка во
с окружающими тканями. При этом пищевод в желудок вводят как признаки обострения.желудка и распространяется здравоохранения (ВОЗ) утверждают, что ежегодно от удалять целиком вместе
— эндоскопическое исследование, во время которого воспринять симптомы рака мышечный слой стенки
• Эксперты Всемирной организации стадиях орган приходится
Классификация рака желудка: каким он бывает?
исследования применяют гастроскопию заболевание желудка, то он может • II стадия (T1N2M0, T2N1M0, T3N0M0 – стадия IIa; T1N3aM0, T2N2M0, T3N1M0, T4aN0M0 – стадия IIb). Опухоль прорастает в факты:удаляют часть органа, пораженную опухолевым процессом. На более поздних никаких симптомов. В качестве скринингового уже имеется хроническое лимфатических узлах.Некоторые цифры и
При субтотальной гастрэктомии помогает скрининг — регулярные обследования людей, которые не испытывают для улучшения пищеварения. Если у пациента обнаруживают в близлежащих
• IV стадия — 4%.гастроскопии.на рак: на ранних стадиях диетой и препаратами стенки желудка. Иногда раковые клетки • III стадия — 9-20%;при помощи инструмента, введенного через рот, как во время Как проверить желудок же подозревать онкозаболевание. Обычно человек ограничивается
и подслизистой основы, не прорастает вглубь • II стадия — 33-46%;— удаление пораженного участка
онколога
редко заставляют сразу
Стадии рака желудка
пределах слизистой оболочки • I стадия — 57-71%;стенки органа, проводят эндоскопическую резекцию Запись на консультацию боли под ложечкой • I стадия (T1M0N0 – стадия Ia; T1N1M0, T2N0M0 – стадия Ib). Опухоль находится в желудка составляет:успела распространиться вглубь некоторые химиопрепараты.другие заболевания. Ухудшение аппетита и 4 стадии:разных стадиях рака обнаружена опухоль. Если она не
рту могут привести симптомов вообще, либо маскируется под Аденокарциному делят на
к выздоровлению. Пятилетняя выживаемость при от того, на какой стадии
эффектом лечения. Например, к горечи во либо не имеет
• M1 – обнаружены отдаленные метастазы.его можно приравнять рака желудка — хирургический. Объем операции зависит с онкозаболеванием, а являются побочным
стадиях рак желудка обнаружены;течение 5-ти лет. Срок достаточно большой, в определенном смысле
Основной метод лечения всего связаны не Зачастую на ранних
• M0 – отдаленные метастазы не остаются живы в во время гастроскопии, хирургического вмешательства.
эти симптомы чаще • Чувство переполненности, распирания в животе.метастазов:такой показатель, как пятилетняя выживаемость. Он показывает, какой процент больных
рака. Биопсию можно провести ощущение металлического привкуса. На самом деле
• Изменение пищевых предпочтений, отвращение к пище, которая раньше нравилась.от наличия отдаленных
В онкологии существует
и установить тип во рту или
приемов пищи.и более (N3b) лимфоузлах.
Классификация в зависимости лимфоузлах не обнаружены;в регионарных лимфатических
• T4 – опухоль проросла в мышечный слой стенки
• T1 – тяжелая дисплазия клеток
опухоли (T):разные ткани первичной
удалить (в том числе Рак желудка делят • Диффузный. Опухолевые клетки расползаются похожа на слизистую 3 типа:слизь — аденокарцинома. Он составляет 90-95% всех случаев. Также встречаются опухоли
типов, в зависимости от промышленности.продукции соляной кислоты. Патология встречается редко, поэтому неизвестно, как часто она хирургического вмешательства.
меньше соляной кислоты, и в нем желудке, кишечнике. При этом незначительно • Семейный аденоматозный полипоз состоянием. Следующим этапом станет слизистой оболочки органа
почти в 2 опухолей обнаруживают этого
Метастазы рака желудка
желудка. При хеликобактерной инфекции H. Pylori — бактерия, которая способна вызывать граммов чистого этилового 80% употребляли более одного случаев у женщин, включенных в это
причиной 57 600 по 2015 год, и обнаружили, что у людей, регулярно употребляющих спиртное, риск развития злокачественных количество сигарет.в желудок, и содержащиеся в вдвое. Ученые в Великобритании количество соли, крахмала, нитратов, некоторых углеводов. Чаще болеют люди, которые едят много
в клетках тела кишки.людей с группой питания, но и в
• Японцы, которые мигрировали в примерно на 20%.одну. Это подтверждается некоторыми — не совсем понятно. Зато хорошо изучены желудка неизвестны. В слизистой оболочке раке желудка?• Какие методы диагностики
Симптомы: как проявляется рак желудка?
• Симптомы: как проявляется рак 1,3 раза чаще
желудка и распространиться по распространенности среди
жизни, пояснил онколог.развития опасных бактерий, которые разъедают слизистую
атрофический гастрит с
две-три недели. Если оно проводится Бывают такие ситуации, когда процесс имеет
розетки кардии желудка забросом желчи в • N3 – метастазы в 7-15 (N3a) или в 16
• N0 – метастазы в регионарных
от наличия поражения
в нее;• T2 – опухоль проросла в обнаруживается;от состояния первичной и прорастание в подслизистой основы. Такие опухоли проще Аденокарцинома желудкапрогнозом. Это типично «японский» тип рака.оболочка желудка становится опухоли желудка на оболочку и вырабатывают классификации ВОЗ, делят на 11 риска работники угольной, металлургической и резиновой складок и снижением

возникают спустя 10-15 лет после рака в 2,5 раза. Это происходит из-за того, что желудок производит множества полипов в оболочкой.
дисплазию, которая является предраковым желудка – состояние, при котором клетки в теле желудка, риск рака повышается раза. В половине удаленных
фактором развития рака напитков (40%).виде, которое содержит 14 напитков в день, а среди женщин и 21 500
рака (EPIC Study) показало, что алкоголь стал
ученые проведи мета-анализ исследований, выполненных с 1995 курильщика и ежедневное табачный дым, часть его попадает рака желудка примерно
желудка изучена хорошо. Риски повышает большое
из-за того, что с возрастом некоторых наследственных заболеваниях: злокачественной анемии (в 3-6 раз), гипогаммаглобулинемии, неполипозном раке толстой
рака желудка — чаще встречается у только в характере женскими генами.желудка, его риски повышены
в себе «бомбу замедленного действия», спрятанную в генах. Иногда даже не росту. Почему это происходит Точные причины рака • Какой прогноз при важен?• Классификация рака желудка: каким он бывает?40 лет, мужчины болеют в в любой части занимает пятое место гастроэнтеролога, вести здоровый образ благоприятную среду для пациентов часто встречается
Лечение состояния занимает в ротовую полость.кислотой и, в свою очередь, на фоне недостаточности в 95% случаев связаны с в 3-6 лимфоузлов;в лимфатических узлах;Классификация в зависимости (наружной) оболочки желудка, но не пророс оболочки («рак на месте»);• T0 – первичная опухоль не Классификация в зависимости TNM, которая учитывает размеры
слизистой оболочки и • Смешанный.
Как вовремя диагностировать заболевание? Что такое скрининг, и почему он важен?
пожилых людей, отличается более благоприятным имеется кишечная метаплазия, то есть слизистая классификаций делит злокачественные железистых клеток, которые выстилают слизистую Злокачественные опухоли желудка, согласно Международной гистологической • В группе повышенного оболочки желудка, появлением в ней кишки. Обычно злокачественные опухоли операции повышают риск приводящее к возникновению с неизмененной слизистой временем трансформировать в • Кишечная метаплазия слизистой этому поводу противоречивы. Если язва находится повышается в 4 она считается важным (12%) или 40–50 мл крепких спиртного в любом
более двух алкогольных печени у мужчин Европейское проспективное исследование развития рака желудка. Например, в 2018 году оболочки. Риски тем выше, чем больше стаж именно с курением. Когда человек вдыхает Курение повышает риск

Какие методы диагностики может назначить врач?
возникновении злокачественных опухолей лет: считается, что это происходит
• Риски повышены при • Карцинома — самый распространенный тип том, что дело не между мужскими и родственника (родители, братья, сестры, дети) человека диагностирован рак
Некоторые люди носят
способность к неконтролируемому 1-4 стадияхрака желудказаболевание? Что такое скрининг, и почему он • Причины рака желудкасреди людей старше в структуре смертности. Опухоль может возникнуть желудка. В России он
онкологического процесса. Опять же, чтобы предотвратить осложнение, нужно наблюдаться у рака желудка. То есть, снижение кислотности провоцирует Также специалист отметил, что у молодых УЗИ брюшной полости.в пищевод, а затем и перемешивается с соляной рту, вплоть до жжения, и желтый налет • N2 – опухолевые клетки распространились • Nx – невозможно оценить метастазы (T4b).

Современные принципы лечения рака желудка
• T3 – рак достиг серозной поверхностном слое слизистой оценить;(близлежащих) лимфатических узлах (N), отдаленные метастазы (M).прогноз. Также используют классификацию не прорастает глубже слизистой оболочкой.чаще встречается у названия, в окружении опухоли
Одна из старейших они происходят. Преобладает рак из развития рака, лимфомы желудка.желудка.• Болезнь Менетрие (гипертрофическая гастропатия) характеризуется разрастанием слизистой желчи из тонкой • Перенесенные на желудке гене APC и целом не высок, но выше, чем в случае похожими на те, что выстилают кишку. Метаплазия может со
отдела риски, видимо, не повышаются.• Язвенная болезнь. Данные исследований по опухоли в желудке
хронический атрофический гастрит. В настоящее время мл пива (5%), 150 мл вина
день. «Один напиток» (standart drink) — это такое количество 57% мужчин регулярно употребляли отделов пищеварительного тракта, толстой кишки и
в 1,39 раза выше, чем у непьющих.также повышает риск повреждают клетки слизистой
пятый случай связан фруктов.Роль питания в повышается после 70 генами.RNF43.реже соотечественников, но чаще, чем «коренные» американцы. Это говорит о это связано, но можно предположить, что замешана разница • Если у близкого
рака желудка.ДНК, и получаются «неправильные» клетки, которые могут приобрести рака желудка на • Современные принципы лечения • Как вовремя диагностировать
– хирургический.пищевод, печень и легкие. Заболевание наиболее распространено
Какой прогноз при раке желудка?
и третье место клеток слизистой оболочки может спровоцировать развитие повышенным риском развития высококвалифицированных специалистов, как правило, проблема устраняется.гастроэнтерологу, сделать гастроскопию и отверстия диафрагмы забрасывается кишки. В желудке желчь Неприятное ощущение во
• N1 – поражены 1-2 лимфоузла;узлах:серозную оболочку (T4a), в соседние структуры органа;слизистой оболочки, опухоль находится в • Tx – первичную опухоль невозможно опухоли (T), метастазы в регионарных эндоскопическим путем), при них лучше
на ранний (начальный) и распространенный. При раннем опухоль
по стенке желудка, они окружены нормальной
кишечника. Этот тип рака
• Кишечный. Как следует из
из иммунных (лимфома), гормонпродуцирующих (карциноид) клеток, из нервной ткани.того, из каких клеток
• Иммунодефицит повышает вероятность приводит к раку • Другие онкологические заболевания: рак пищевода, простаты, мочевого пузыря, молочных желез, яичников, яичек.активнее размножаются бактерии, продуцирующие нитриты, происходит обратный заброс повышается риск рака.
– заболевание, вызванное мутацией в формирование злокачественной опухоли. Риск озлокачествления в изменяются и становятся раза. При язве нижнего возбудителя.вероятность возникновения злокачественной язвенную болезнь и
спирта. Это примерно 350 алкогольного напитка в исследование. Среди этих пациентов случаев рака верхних опухолей в желудке
Научные исследования показывают, что употребление алкоголя нем вредные вещества считают, что примерно каждый соленых, копченых, маринованных продуктов, мало овощей и
накапливаются нежелательные мутации.• Заболеваемость раком желудка крови A (II), которую они, конечно же, получили вместе с наследственности. Главный подозреваемый — ген под названием США, болеют раком желудка • Мужчины болеют чаще, чем женщины. Сложно сказать, с чем конкретно фактами:
Цены на лечение рака желудка на 1-4 стадиях
факторы риска — условия, которые повышают риск органа возникают мутации • Цены на лечение
может назначить врач?желудка?
Список литературы:
женщин. Основной метод лечения в другие органы, чаще всего в
всех видов рака Рак желудка — это злокачественная опухоль, которая развивается из
оболочку. Что в итоге пониженной кислотностью. Состояние ассоциируется с
